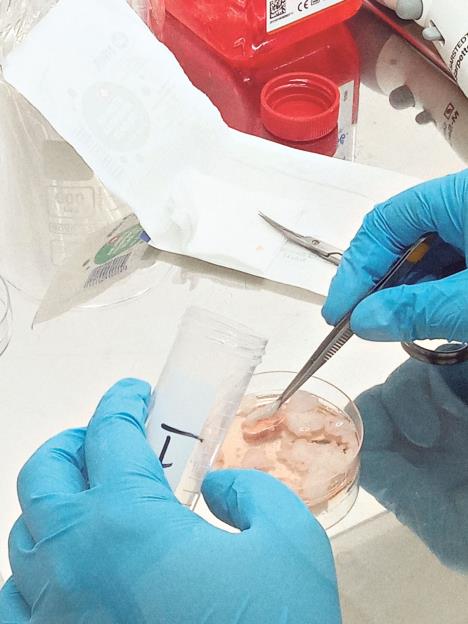
1003-startno-tkivo-za-izolaciju.jpg

OVO JE INOVATIVAN NAČIN DA SE SALO PRETVORI U MAŠINU ZA MRŠAVLJENJE: Srpski naučnici dokazali veliku stvar!

Uprkos brojnim dijetama i lekovima koji se koriste za smanjenje telesne težine, broj gojaznih osoba je svakim danom sve veći! Razlog tome je i što je kod gojaznih osoba značajno smanjena aktivnost mrkog masnog tkiva - jedinstvene "mašine" za sagorevanje kalorija. Srpski naučnici su dokazali da se, uz bezbedne elemente po ljudsko zdravlje, takozvanim procesom brauninga (od eng. browning) ćelije u belom masnom tkivu koje ne sagorevaju kilograme mogu pretvoriti u one koje to čine.

Dr Aleksandra Janković sa Odeljenja za fiziologiju Instituta za biološka istraživanja "Siniša Stanković", instituta od nacionalnog značaja za Republiku Srbiju, za Kurir najpre objašnjava da je tzv. mrko masno tkivo primarno zaduženo za proizvodnju toplote (termogenezu).
- Zahvaljujući specifičnim osobinama, mrko masno tkivo hemijsku energiju iz hrane troši na dobijanje toplotne energije. S obzirom na to da se toplota nepovratno gubi, na ovaj način se rasipaju kalorije. Aktivacija mrkog masnog tkiva smanjuje gojaznost, insulinsku rezistenciju i hiperlipidemiju kod miševa, a studije na ljudima pokazale su da oni koji ga imaju više, imaju i manje izglede za dijabetes tipa 2. Neke ćelije u belom masnom tkivu se pod specifičnim uslovima mogu transformisati u ćelije mrkog masnog tkiva. Takve ćelije se zovu inducibilni ili bež adipociti, a sam proces transformisanja belog u mrko masno tkivo je poznat kao brauning. To je nov, inovativan pristup za povećanje sagorevanja lipida u belom masnom tkivu, što može pomoći ne samo u mršavljenju već i održanju normalnog nivoa lipida u krvi - navodi dr Janković.
Projekat WARMED, na kome srpski naučnici rade već dve godine, treba da bude dobra osnova za buduća klinička ispitivanja koja bi pomogla da se razviju nove terapije za borbu s gojaznošću.

- Primenili smo poznavanje biologije slobodnih radikala u nastojanju da od belih adipocita, koji su termogeno inertni i ne mogu da sagore masti, dobijemo termogeno aktivne ćelije koje će ih sagorevati. U eksperimentima smo bili usredsređeni na razvoj i kontrolu bež adipocita kroz modulaciju nivoa tzv. redoks-aktivnih molekula koji se produkuju u masnom tkivu. Poseban akcenat bio je na ispitivanju uloge azot oksida u stimulaciji brauninga - kaže dr Janković.
U istraživanjima su radili in vivo studije na pacovima i najizazovnije in vitro studije na ćelijama belog masnog tkiva pacova i ljudi.

- Najpre smo ispitali nivoe azot oksida u adipocitima koji podležu brauningu kada pacove izložimo niskoj temperaturi (oko 4° C), najjačim prirodnim stumulusom brauninga. Na ljudima se ovakva ispitivanja obavljaju samo na umereno niskim temperaturama (16° C), gde su najnovije kliničke studije pokazale pozitivan efekat npr. u koterapiji kancera. Potom smo suplementacijom, tj. korišćenjem nekih aminokiselina koje se već koriste kod ljudi, kao što je arginin, pokazali da možemo indukovati brauning u belom masnom tkivu pacova. U poslednjem, metodološki najzahtevnijem delu, uhodali smo in vitro protokole pomoću kojih možemo doći do bež adipocita. Reč je o jedinstvenom pokušaju da se inertni beli adipociti i stem ćelije izolovane iz belog masnog tkiva, u laboratoriji in vitro, posredstvom redoks-zavisnih mehanizama remodeliraju do termogenih bež adipocita - objašnjava dr Janković.
Rezultati su, ističe, doprineli fundamentalnim naučnim saznanjima koji su od posebne važnosti u oblasti gojaznosti.
- Očekujemo da će ovi rezultati podstaći i ubrzati nove pristupe u medicini i farmakologiji u oblasti metaboličkih bolesti koje su povezane s gojaznošću. To podrazumeva primenu supstanci za stimulaciju procesa brauninga, koje se bezbedno koriste kod ljudi, kao i postupka za dobijanje ćelija koje bi se koristile u autolognoj transplantaciji, što znači da se izolovane ćelije tretiraju u veštačkim uslovima i vrate u organizam - navodi dr Janković i dodaje da je ovo istraživanje publikovano u vrhunskim časopisima.
Kurir.rs/J. S. Spasić



